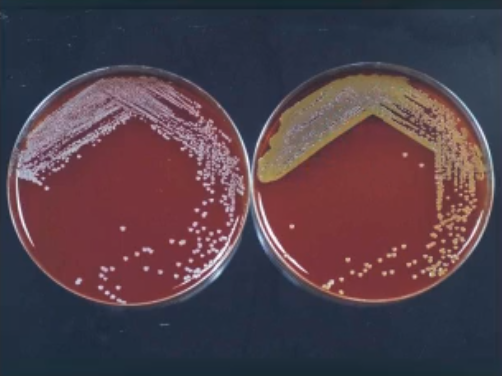
<ul><li><p>staphylococcus epidermidis</p><ul><li><p> skin</p></li></ul></li></ul><ul><li><p>staphylococcus aureus</p><ul><li><p>nose</p></li></ul></li></ul><p></p>

Bacteriology and Oral Diseases; pptx 8
1/116
Earn XP
Description and Tags
pathogenies and strep
Name | Mastery | Learn | Test | Matching | Spaced | Call with Kai |
|---|
No analytics yet
Send a link to your students to track their progress
117 Terms
Pathogenicity
The ability to cause disease
Virulence
The extent of pathogenicity
Attenuation
The decrease or loss of virulence; attenuated bacteria or virus can be made to be studied or for injections to expose to body
ID50
Infectious dose for 50% of the test population
LD50
Lethal dose (of a toxin) for 50% of the test population
Susceptibility
Lack of resistance to a disease
Resistance
Ability to ward off disease
Nonspecific resistance
Defenses against any pathogen; basically innate immune system
Specific resistance
Immunity, resistance to a specific pathogen; basically adaptive immune system
portals of entry for virulent organism
Respiratory tract
blood and vector-borne
urogenital tract
ocular surface
gastrointestinal tract
skin
T/F if bacteria enter into any one of these portals of entry, they are guaranteed to infect the host
False, there are many mechanism in each portal of entry that can still block the bacteria
First line of defense
Intact skin
mucous membranes and their secretions
they shed (coughing, etc) getting rid of bacteria
normal microbiota
Second line of defense
phagocytic white blood cells
inflammation
fever
antimicrobial substances
Third line of defense
specialized lymphocytes: B cells and T cells
antibodies
what parts are non specialized? (first line of defense, second line of defense, Third line of defense)
first line of defense and second line of defense
what parts are specialized? (first line of defense, second line of defense, Third line of defense)
Third line of defense

what can this image show u?
this shows u the different mechanisms in different cavities that can block bacteria, etc
*good reference
skin
epidermis consists of tightly packed cells with keratin (protective portein)
Mucous membranes
ciliary escalator: microbes trapped in mucus are transported away form the lungs
lacrimal apparatus: washes eye
saliva: washes microbes off
Urine: Flows out
Vaginal sections: flows out
Chemical factors
fungistatic fatty acid in sebum
lysozyme in perspiration, tears, saliva, and tissue fluids
low pH (1.2-3.0) of gastric juice
transferrin’s in blood find iron
Nitric oxide inhibits ATP production
Normal microbiota
Microbial antagonism/competitive exclusion: normal microbiota compete with pathogens
*this is really important in preventing disease, when bacteria are wiped of when taking antibiotics u become very susceptible to infection
what are the characteristics that a pathogen needs?
need to be able to be exposed to other organisms
ability to adhere
ability to invade
ability to colonize and grow
either invasive or toxic
this results in tissue damage and/or disease
how can we see how a pathogen goes through the body
using bioluminescence(this emits a light that can be detected) or fluorescents(needs to shine a light directly). tagging the pathogen and seeing the light go through the body; IVIS
non-specific colonization mechanisms
does not require receptor (e.g capsule, EPS, things that can stick)
specific colonization mechanisms
requires receptors
Adhesions/ligands bind to receptors on host cells
good review for other bacteria’s and their specifics for binding

Host immune evasion
ability to avoid phagocytosis
intercellular growth
production of proteases(enzymes in general) against antibodies
biofilm and microbial cell clusters (such as in UTI’s)
some bacteria, this is the only virulence factor they have

Enzymes produced by pathogens
pathogens produce a variety of enzymes that enhance virulence by breaking down or altering host tissue to provide access and nutrients
*pic has examples of enzymes

Coagluase
coagulate blood
Kinases
Digest fibrin clots
hyaluronidase
hydrolyses hyaluronic acid
collagenase
hydrolyzes collagen
IgA proteases
destory IgA antibodies
siderophores
take iron from host, iron - bring proteins
antigenic variation
alter surface proteins; *not an enzyme
protease
breaks down proteins; can also sometimes use the pieces of the broken down protein as a food source
Toxin
Substances that contribute to pathogenicity
Toxigenicity
ability to produce a toxin
toxemia
presence of toxin the host’s blood
toxoid
Inactivated toxin used in a vaccine
Antitixon
antibodies against a specific toxin
if you are infected to a bacteria that produces a toxin in your body what do physicians do?
they will give you an antibiotic for the bacteria and an antitoxin for the toxin the bacteria produced
Exotoxins
toxins that are produced and secreted form bacteria
produced by living/growing cells
the toxins are always proteins
they do not cause fevers
can be neutralized by antitoxins/antibodies
have a small LD50
very toxic
what is the source of exotoxins in bacteria?
mostly gram +, but some gram - can also produce them
what are the different categories of exotoxins
cytolytic toxins
AB toxins
Superantigen toxins
cytolytic toxins
secreted soluble toxins that damage host cells cytoplasmic membranes causing cell lysis, basically your homolosine
proteins that are secreted by bacteria
e.g type 1 secretion system
will bind to the phospholipid of the host membrane (on slide)
bind to membranes of mammalian cells(lipid) and puncture a hole in the cell causing it to lysis(Dr. Kadouri’s words)
this is done to scavenge the fe from the RBC
what is an example of a bacteria that produces a cytolytic toxins
aa or A. actinomycetemcomitans; they produce a leukotoxin, acts as a virulence factor as a means to protect itself from pnms/white blood cells
leukotoxins
cytolytic toxin that is produced and secreted by cytolytic toxin A. actinomycetemcomitans (aa) and is a protein that can bind to white blood cells ———- specifically to activated pnms (bind to lymphocyte function antigen - 1 (LFA-1) on the pnms which is what allows the pnms to go into tissues from blood)
binds to LFA-1 and inserts into target cell membrane
several LtxA monomers multimerize and form a pore or disruption in membrane
pore/disruption causes leakage or membrane collapse
at high doses LtxA = necrosis (holes in membrane); low doses = apoptosis
basically exotoxins that bind to and disrupt the membrane on cells, basically melting it
at high doses LtxA
causes necrosis (holes in membrane)
low doses of LtxA
causes apoptosis
what are pnms?
polymorphonuclear leukocytes; involved in:
Phagocytosis: PMNs engulf and destroy pathogens, such as bacteria and viruses.
Inflammation: They release chemicals that promote inflammation, attracting other immune cells to the site of infection.
Tissue repair: PMNs help clean up debris and damaged cells, facilitating tissue healing.
Maintaining homeostasis: PMNs help regulate the immune system and prevent excessive inflammation.
AB toxins
toxin that consists of 2 subunits, which work together to bind, infiltrate and inhibite protein synthesis
why are AB toxins called AB toxins?
because it conceits of 2 subunits, A and B
AB toxins - A
crosses the membrane thanks to the help of B and plays a role in inhibiting protein synthesis
AB toxins - B
binds to host cell surface receptor and facilitates the transfer of the A subunit across the membrane
what kind of toxins does diphtheriae secrete?
AB toxins
diphtheriae
gram + bacteria that usually causes infection on mucal membranes (usually in throat and sometimes in GI tract) and will be distributed throughout the body that can cause heart, liver kidney damage. death is causes by the actual toxin and can be treated using a antitoxin and antibiotic
there is a vaccine for it that most peopel have taken
what kind of a toxins are botulinum and tetanus toxins and what bacteria produces them?
Clostridium botulinum produces them and they are AB toxins
botulinum and tetanus toxins
very potent neurotoxin, 1mg can kill >1 million guinea pigs (humans 2 nanograms per kg of bodyweight)
the spreading of the toxin will cause paralysis leading to death
how does botulinum toxin work?
will bind to presynaptic membranes on motor neurons at neuromuscular junctions and block the release of acetylcholine, acetylcholine is responsible for muscle contractions and this can cause many issues like trouble breathing, etc. basically causes a paralysis
how is Botox done?
It is done by injecting toxins(usually botulinum toxin) into the muscle nerves which relaxes the muscles; wrinkles form due to muscle contractions in that area, if you relax the muscle they will go away
what kind of issues can arise form incorrect use of botox?
too much can kill the nerve
wrong spot injected can have face paralysis
tetanus toxins
AB exotoxin, neurotoxin; transported to neurons in the spinal cord to bind to ganglioside lipids which then blocks glycine release which is important for inhibition of neurotransmitters. This will lead to an over accumulation of acetylcholine which will lead to twitching paralysis and muscles which are constantly contracting; treated with antibiotics and antitoxins
what is the first sign of tetanus toxins?
locked jaw
Enterotoxins
exotoxins that specifically affect the small intestine, causing changes in intestinal permeability that lead to diarrhea and vomiting
can be caused by Gram + or -
what causes food poisoning?
bacteria that grow in the GI tract or the toxins that bacteria produce (Enterotoxins)
T/F Enterotoxins are AB toxins
True
how do Enterotoxins work?
the b subunit binds to GM1 which are glycolipids on the membrane of intestinal epithelial cells this causes a chain to activate adenylate cyclase which is an enzymes what converts ATP to cAMP which regulators cell compounds involved in ion balance. When cAMP levels go up, chloride ions are secreted to the lumen and water follows it into the lumen resulting int massive amounts of fluid loss and sever diarrhea
messes with regulatory compounds for ion balance (increase in cAMP)
causes salts to leave the the blood instead of go into the blood
water flows the salt into the lumen of the small intestine (GI tract)
a lot of water loss
*a representation of what normally happens in lumen of intestines is shown in picture

Superantigen toxins
a toxin capable of over-activating the immune system which can cause toxic shock syndrome. These toxins directly bind to MHC-II and TCR and bridging them, which puts theses complexes in contact with each other for much longer than normal causing T cells to release a large number of cytokines. this cytokine storm is what causes toxic shock syndrome
overstimulate the immune system
causes toxic shock
*25 superantigens known to date
endotoxins
only produces by gram (-) bacteria; they are the LPS on gram (-) bacteria
works very similarly to superantigens in that it over stimulates the immune system putting you in septic shock
they are NOT secreted, they are on the surface of the cell, can still be present on dead cells and still stimulate an immune response
they are made of sugars, not proteins
can cause fever and increase permeability of blood vessels, lowering bp
the lowering of bp will cause septic shock and the lower of bp basically causes organ failer
can also cause platelets to aggregate which can cause blood clots, which can lead to a stroke

looking at this picture of a LPS (endotoxin) what part(s) induces the toxic effect?
the lipid A portion (yellow)

looking at this picture of a LPS (endotoxin) what part(s) make the complex water soluble?
the o-specific polysaccharide and core polysaccharide (purple and red)

what part of the LPS stabilizes the molecule?
the core polysaccharide (red)

what part of the LPS does the body make antibodies against when u are vaccinated?
the o-specific polysaccharide (purple)
what is something that endotoxins/LPS do that exotoxins don’t and why?
produce a fever and this is because macrophages take in the bacteria and as a response to the LPS will produce cytokines (IL-1, Interleukin - 1 ) which will inducing the hypothalamus to produce prostaglandins, raising your temperature (fever)
T/F Endotoxins are proteins just like exotoxins
false, they are sugars
Limulus amebocyte lysate assay (LAL)
this assay is used to check to make sure no LPS is present when making drugs from bacteria, etc.
amebocyte from horseshoe crab are used to detect endotoxins
presence of endotoxins cause aggregation and lysis of amebocyte to extract a precipitating gal
can detect as little as 10pg/ml lps

chart comparing endo- and exo- toxins
REVIEW, REVIEW, REVIEW

salmonella virulence factors (said u don’t have remember this? 0:41:42, last lecture video with kadouri)
has many virulence factors
causes food poisoning
have siderophores
produce enterotoxins
LPS
capsule
pili and fimbria
virulence plasmid, allowing for resistance or changing or gene expression
phylogeny of Gram + bacteria
low G+C
High G+C
level of G and C in DNA
low G+C gram positive bacteria
mycoplasma
bacillus
staphylococcus
streptococcus
Lactococcus
enterococcus
lactobacillus
clostridium
high G+C gram positive bacteria
mycobacterium
streptomyces
Viridians streptococci
streptococcus
Lactococcus
enterococcus
lactobacillus
all produce acid and associated with caries
staphylococcus bacteria
(mainly staph aureus), these are the bacteria that cause the most infections in humans out of all other G+ bacteria, kills thousands of people all the time because of how many virulence factors these bacteria have
rounds cells that are clustered together
staph - cluster together
coccus/cocci - round cells
G +
0.5-1.5 um
nonmotile (nonflagilated)
factitively anaerobic
can be found causing infection in many different parts of the body
can grow in high salt (10% NaCl)
18 - 40 degrees C
explains why they can cause a lot of food poisoning
part of the normal flora (nasal, skin)
bc can grow in higher salt areas
what the are 2 most important staphylococcus bacteria for humans in infection and where do they grow
staphylococcus epidermidis
skin
staphylococcus aureus
nose
staphylococcus epidermidis virulence factors
does not have a lot of virulence factors and it mainly only has the ability to:
poly-N-acetylglucosamine
allows for attachment to biomaterials
biofilm formation
protection from antimicrobial killing
protection form phagocytosis
make a very thick EPS/biofilm
most infections are device related
was always considered a commensal bacteria(not pathogenetic) but when started to use more medical devices can be accidentally injected into body making it a pathogen
staphylococcus epidermidis can cause what kinds of infections?
cause infections in device infections
cause bacteremia
staphylococcus aureus can cause what kinds of infections?
skin infections
Device infections
infections in people that have Burn and wound
pneumonia - lung infection
urinary tract infections
bacteriemia
necrotizing fasciitis - produce proteolytic enzyme (breaks down tissue)
meningitis - brain infection
Osteomyelitis - bone infection
endocarditis
sepsis
food poisoning
toxic shock syndrome
staphylococcus aureus virulence factors allow it to do what?
survival in many different environment
invasion and attachment
surface/cell/tissue attachment
avoiding the immune system and immune detection
avoiding opsonization
avoiding phagocytosis
cell invasion
produce toxins
produce enzymes
staphylococcus aureus virulence factors ( there a SOOOOOO MANY)
can be transferred from touch
can survive in many different environments
produce a capsule (all do)
avoid immune system
bind to tissue
ability to produce a slime layer
good for forming a biofilm
very thick peptidoglycan
more resistant to desiccation and stresses
50% peptidoglycan in weight
in MRSA mecA codes for PBP2 that doesn’t bind penicillin
another penicillin binding protein
can help prevent antibiotics and other mechanisms from entering
has huge amount of proteins on surface allowing for the binding on almost anything on body
Teichoic acid
run through entire peptidoglycan
MSCRAMMS
microbial surface components recognizing adhesive matrix molecules
laminin binding protein
fibronectin binding protein
collagen binding protein
elastin binding protein
has peptidoglycan associated protein
protein A - mechanism to avoid immune system
coats the surface of S. Aurus
very high affinity for binding the Fc receptor of IgG
v structure binds to bacterial surface on the opposite configuration, making the antibody nonfunctional
can prevent opsonization and phagocytosis
can inhibit antibody mediated clearance
coagulase - forms blood clots around the bacteria, protecting it
cell bound clumping factor - surface protein on S. aureus
cell free coagulase
converts fibrinogen to insoluble fibrine, which causes clumping and aggregation
coagulase - can cause the formation of a protective fibrin layer around the cell
Extracellular enzymes (these allow for breaking down of tissue)
staphylokinase- dissolves fibrin clots
not all staph have this
hyaluronidase - hydrolyzes hyaluronic acid in connective tissue
lipase - hydrolyzes lipids
deoxyribonuclease - hydrolyzes DNA
Fatty acid modifying enzyme (FAME)
a lot of different exotoxins (4 different hemolysins it can produce)(toxins that puncture membranes)
α toxin (α hemolysin)
produced by most S. aureus strains
toxic to many cells
forms pores in cell membrane and causes tissue damage
β toxin
produced by most S. aureus strains
hydrolysis of membranes
δ toxin
produced by all S. aureus strains
nonspecific membrane toxin
γ toxin
produced by most S. aureus strains
lyse neutrophils and macrophages
additional exotoxins (not hemolysins)
Exfoliating toxin - protease (break down tissue)
serine protease that can degrade structural component of the epidermis
staphylococcal scalded skin syndrome (SSSS)
can grow deep in skin and this can happen
secondary infection can form after or during
enterotoxins - major water loss
associated with food poisoning
heat stable - 10 degree C 30 min
resistant to gastric enzymes
causes inflammation of the gastric tissue, diarrhea and vomiting
TSST-1
toxic shock syndrome toxin -1
superantigens, which bind to macrophages and interact with T-cells and results in the release of cytokines-shock and high fever and organ failure
reason for changing of tampons

what is this picture showing?
it is a summary of the virulence factors of staphylococcus aureus without the specific details

how to test for S. aureus?
coagulase identification test, taking the bacteria samples on slide, mixed with rabbit plasma/serum, then put into tube. If S. aurus will produce coagulase making a blood clot like gel at the bottom of the tube

if you are testing a bacteria and it is catalase positive and coagulase positive, what bacteria is it?
S. aureus; the catalase positive tells you it a staphylococcus bacteria and coagulase positive is a trait of aureus bacteria giving you that conclusion
what staphylococcus aureus strains are the worst
HA-MRSA (hospital acquired) (methicillin resistant staph aureus)
can usually be acquired in hospital settings
typically found in immunodeficient patients
need to use gentamicin for treatment
IV
CA-MRSA
Community acquired
can be found almost anywhere
typically found in healthy individuals
looks like a spider bite on skin

how can u tell the difference between streptococcus and staphylococcus?
by performing catalase test, putting both bacteria on a glass and putting hydrogen peroxide on top, if the sample begins to fizzle and get bubble means it produces catalase and is able to break down hydrogen peroxide, this makes it the staphylococcus bacteria

S. Mutans virulance factors
transmitted from main care giver
adherence to tooth surface
Antigen I/II - binding to acquired salivary pellicle on tooth surface
GBP - make glucans
GTF - coaggregate and auto aggregate binding with the glucans
production of extracellular polysaccharide
acidogenesis
aciduricity

After step mutans make acidogenic or cariogenic plaque (low pH plaque) what other bacteria come and attach?
Streptococcus sanguis
lactobacilli
Lactococcus
taracoccus
these can make the situation worse as all of these bacteria produce and like to live in acidic environments
what bacteria can form GTF(glucosyltransferase)
streptococcus
Lactococcus
lactobacillus
what biological properties of saliva influence the caries process?
mechanical washing
removes debris of food so bacteria cant ferment it and wash away the bacteria
buffering
buffers the pH, raising the pH, decrease the time of low pH
antibacterial activity
lysozyme
lactoferrin
aggregation of bacteria
IgA
remineralization of enamel
salts (calcium and phosphate)
allowing for recalcification of lesions like white spots
conditions/mechanism associated with mechanical washing in saliva
flow rate
different flow rates in different parts of oral cavity
due to gravity
xerostomia
condition with no saliva flow
takes away the benefits of the saliva
people that take medication
alpha blockers
methamphetamines
circadian rhythm
low saliva flow at night compared to day
reason for bad breath and dry mouth
gives bacteria a good time to ferment if any food is still present and you don’t brush